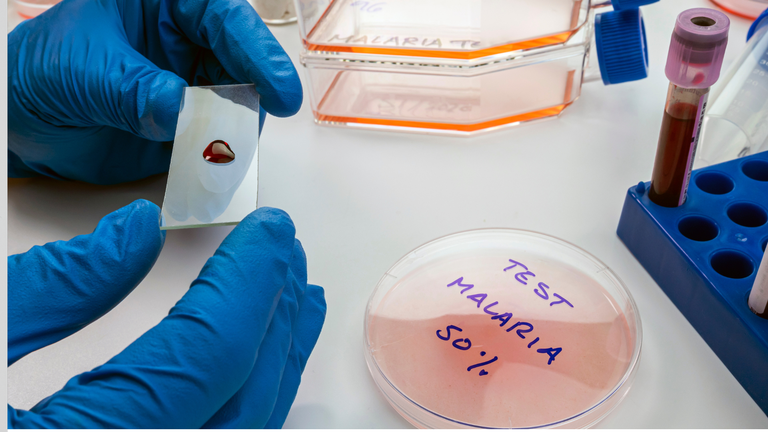
25042024 Luta contra a malária 99% dos casos da doença no Brasil estão na região amazônica 3.png

Galeria de Imagens
SAÚDE
Luta contra a malária: 99% dos casos da doença no Brasil estão na região amazônica
Nesta reportagem, você vai ver que:
Não há transmissão direta da doença de uma pessoa para outra
Viajantes que visitam a região amazônica precisam redobrar a atenção
Teste para detectar tipos de parasita é fundamental para tratamento
Brasil ainda não conta com vacinas, por isso previna-se!
Brasília (DF)- Você sabia que a malária também é conhecida popularmente como maleita, sezão, tremedeira, batedeira ou febre? Ela é típica de países subtropicais e tropicais, como é o caso do Brasil, e sua transmissão em humanos acontece pela picada da fêmea do mosquito-prego (gênero Anopheles), infectadas pelo parasita Plasmodium. De acordo com o Ministério da Saúde (MS), 99% dos casos no Brasil, estão na região amazônica. Para fomentar o controle efetivo da enfermidade, foi instituído pela Organização Mundial de Saúde (OMS), o Dia Mundial da Luta contra a Malária (25 de abril). Nesta matéria, confira as principais informações que envolvem a doença.
A malária é uma doença infecciosa febril aguda, que tem cura e o tratamento está disponível no Sistema Único de Saúde (SUS). Entretanto, se faz necessário um rápido diagnóstico para evitar formas graves da doença. Contribuindo com uma assistência de qualidade, a Rede Ebserh possui hospitais universitários que são referência para esse tipo de atendimento, além de contar com profissionais capacitados para esclarecer sobre a doença, não só em regiões de grande incidência, mas em todo o Brasil.
Não há transmissão direta da doença de uma pessoa para outra
O Hospital Universitário João de Barros Barreto (HUJBB), vinculado ao Complexo Hospitalar da Universidade Federal do Pará (CHU-UFPA/Ebserh), é referência estadual no atendimento à malária, principalmente os casos mais graves. O diagnóstico e o tratamento são realizados Unidade de Doenças Infectoparasitárias (Udip), em pacientes referenciados por meio da Rede de Atenção Básica de Saúde.
O médico infectologista do HUJBB, Jose Eudes de Carvalho Neri, explicou que a malária mais incidente no Brasil é a causada pelo parasita Plasmodium vivax. “No último boletim de dados de 2022 do MS, o vivax era responsável por 84,2% das infecções, mais de 100 mil casos. O segundo agente é o Plasmodium falciparum com 13,9%, com mais ou menos 17 mil casos”, revelou. Segundo ele, há também uma expressiva proporção de pacientes que apresentam infecção mista, causada por dois tipos de espécies, que corresponde a mais ou menos 1,8%, cerca de 2 mil casos.
Complementando as informações, o infectologista Thiago Mendes, do Hospital Universitário de Largato (HUL-UFS), em Sergipe, explicou que, geralmente, o Plasmodium falciparum causa a doença na sua forma mais complicada. “A malária, normalmente, vai se manifestar no organismo com febre, às vezes febre alta, e a depender da gravidade é possível ter uma destruição muito grande das hemácias e isso pode provocar uma anemia importante com disfunção hepática, dano cerebral”, explicou. Segundo o médico, o risco de gravidade é maior principalmente pelo falciparum. Já quanto ao vivax, há pacientes, principalmente os que moram na região que já tem a malária por muito tempo, ou não apresentam sintoma ou só uma febre muito baixa que dura poucos dias, relatou o especialista.
O problema nesses casos é que, às vezes, o paciente contaminado pelo vivax, fica com ele por muito tempo no organismo, mas sem sintoma algum. Entretanto, o parasita continua perpetuando-se pelo sistema. Se essa pessoa for picada por um mosquito e depois esse mosquito picar outra pessoa, vai acontecer a transmissão. Ela não acontece de forma direta de uma pessoa para outra, mas sempre pela picada do mosquito contaminado, esclareceu.
Viajantes que visitam a região amazônica precisam redobrar a atenção
José Eudes (HUJBB) citou os estados do Acre, Amapá, Amazonas, Pará e estados do centro-sul e do Nordeste (Maranhão, Tocantins, Roraima e Rondônia), como locais com maior incidência na região amazônica, em mais ou menos 808 municípios. Já a região extra-amazônica, corresponde a 1% dos casos em sua maioria. “O principal motivo destes casos se concentrarem na região amazônica é a presença do vetor. Então, o plasmodium está dentro de um vetor, que é um mosquito. E a presença desse mosquito mantêm a cadeia de transmissibilidade da doença”, frisou o infectologista.
Entretanto, Thiago Mendes (HUL), chamou a atenção que, embora seja raro nas regiões fora da Amazônia, a malária permeia o Brasil como um todo, onde há alguns focos da Mata Atlântica. Mas o alerta principal é para os viajantes que visitaram a região amazônica.
“Uma pessoa que mora na região e que teve malária diversas vezes tem a chance de ter uma menor gravidade da doença comparado com o viajante. É uma lógica um pouco invertida da dengue. Esta última, quanto mais vezes você pegar a doença, maior chance de você ter uma dengue hemorrágica, já a malária é o contrário. O viajante que vai pela primeira vez e pega malária tem mais chance de ter complicações”, comentou.
Teste para detectar tipos de parasita é fundamental para tratamento
Quanto ao diagnóstico, José Eudes (HUJBB) explicou que, por se tratar de uma doença infecciosa, precisa ter acompanhamento da suspeita clínica, que leva em conta a exposição ao vetor, a exposição às áreas de riscos endêmicas e ao quadro de febre. Além disso, é preciso solicitar um teste laboratorial. “Essa febre é precedida de calafrios, seguida por sudorese profunda, fraqueza, dor de cabeça, que ocorre em padrões cíclicos de 24/48 a 72 horas”, frisou. O teste mais utilizado é o da microscopia direta pela gota espessa (colhe uma gota de sangue da ponta do dedo do paciente). São feitos nos locais de referência, para identificar o tipo de plasmodium e assim realizar o tratamento mais correto.
Entre as unidades da Rede Ebserh, tem também o Hospital de Doenças Tropicais da Universidade Federal do Tocantins (HDT-UFT) que é referência no atendimento da malária em Araguaína e região. O acesso ao serviço é realizado por meio de encaminhamento da Rede de Atenção à Saúde (RAS).
Brasil ainda não conta com vacinas, por isso previna-se!
O infectologista, Jose Eudes (HUJBB), sinalizou que existem estudos para vacina e que a Organização Mundial de Saúde já aprovou duas contra malária em crianças de área endêmica na região da África Subsaariana, Ghana e Quenya. O Brasil ainda não conta com vacinas. Portanto, toda pessoa exposta ao vetor pode desenvolver a doença. Para evitar, recomenda-se o uso de: mosquiteiros; roupas que protejam pernas e braços; telas em portas e janelas; e repelentes. Fica a dica! A Prevenção é sempre o melhor caminho!
Sobre a Ebserh
Vinculada ao Ministério da Educação (MEC), a Ebserh foi criada em 2011 e, atualmente, administra 41 hospitais universitários federais, apoiando e impulsionando suas atividades por meio de uma gestão de excelência. Como hospitais vinculados a universidades federais, essas unidades têm características específicas: atendem pacientes do Sistema Único de Saúde (SUS) ao mesmo tempo que apoiam a formação de profissionais de saúde e o desenvolvimento de pesquisas e inovação.
Por Danielle Morais, com revisão de Danielle Campos
Coordenadoria de Comunicação Social/Ebserh